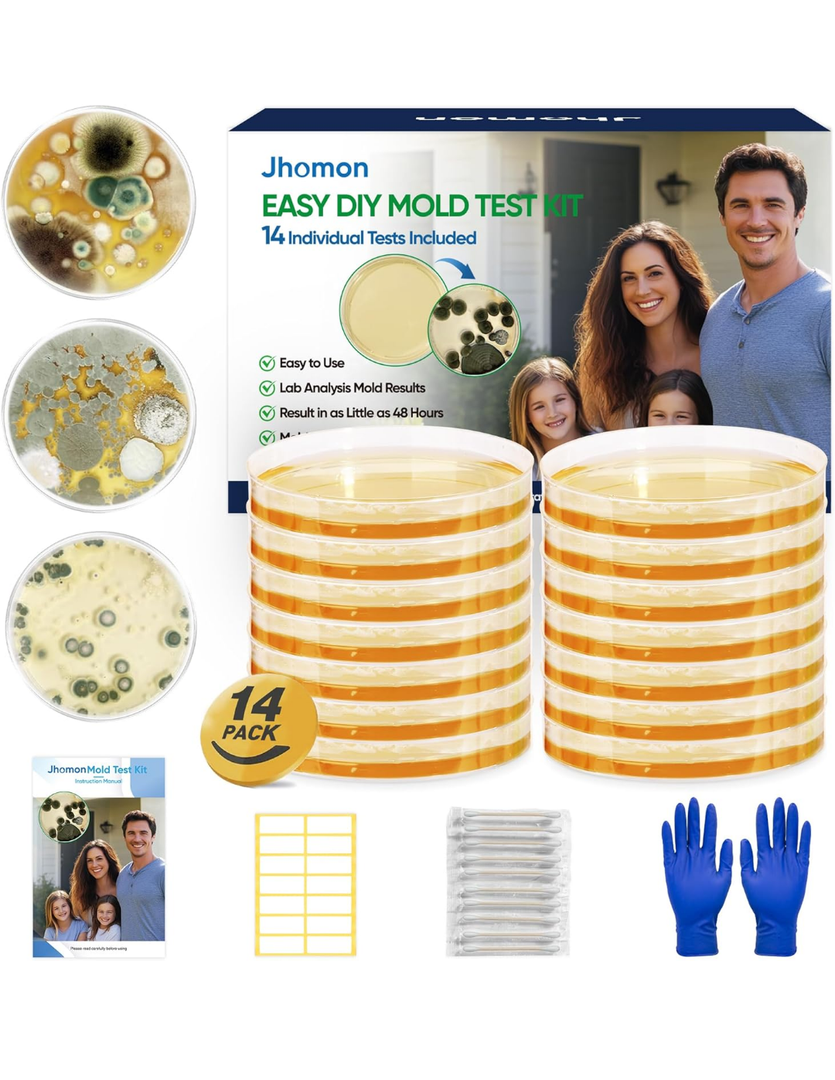
Mold Test Kit for Home, 14 Simple Mold Detectors with Detailed Mold Identification Guide, DIY Mold Testing Kit for Home Surfaces & Indoor Air Quality & HVAC & Car, Results in 48 Hours, 14PCS

Mold Test Kit for Home, 14 Simple Mold Detectors with Detailed Mold Identification Guide, DIY Mold Testing Kit for Home Surfaces & Indoor Air Quality & HVAC & Car, Results in 48 Hours, 14PCS
Condition: Appears New
Pickup Details
| Saturday, Feb 7 | 08:30AM - 02:00PM |
| Monday, Feb 9 | 11:00AM - 06:30PM (Appointment only) |
| Tuesday, Feb 10 | 12:00PM - 06:30PM |
| Wednesday, Feb 11 | 11:00AM - 06:30PM (Appointment only) |
Product Details
| SKU | OLARR6228110 |